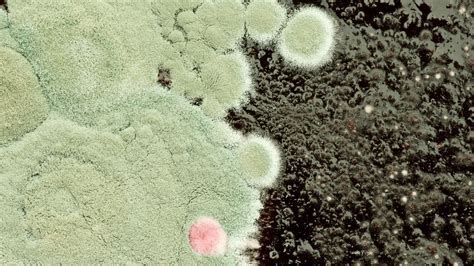
Különböző színű penészgombák
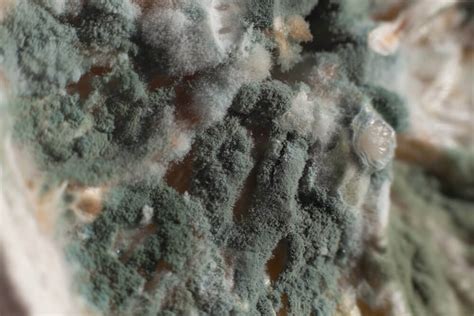
Penész a falon

Az élelmiszerek biztonsága az emberi egészség egyik sarkalatos pontja. Az emberek egy része az élelmiszerekben esetlegesen előforduló kórokozóktól, vegyi anyagoktól (növényvédőszer-, állatgyógyszer-maradékok, adalékanyagok) tart, míg mások az új technológiáktól (genetikailag módosított élelmiszerek) félnek. Az élelmiszereinken megjelenő penészfoltok kapcsán gyakran merül fel a kérdés, hogy mennyire veszélyesek, ehetőek-e még az érintett élelmiszerek, és hogyan előzhetjük meg a penészedést. Ez a cikk részletesen foglalkozik a penész jelenségével, annak okaitól kezdve a lehetséges egészségügyi kockázatokon át a megelőzés és kezelés módszereiig.
Mi is az a penész? Egy kis mikrobiológia
A penész mikroszkopikus gombákból áll, amelyek növényi vagy állati szöveteken, élettelen anyagokon telepszenek meg. A gombák, a növény- és állatvilág mellett, az eukarióta (sejtmaggal rendelkező sejtek) sejtű élőlények harmadik önálló csoportját jelentik. A „penészgomba” név csak megjelenési formát jelent, nagyon különböző mikroszkopikus méretű, szaporodású és életmódú hifafonalas (gombafonal) gombákra vonatkozik, amelyek rendszertani rokonsága olykor nagyon távoli. Túlnyomó részük ivartalanul szaporodik, a spórák szóródását a levegő, víz vagy rovarok biztosítják.
A penész színét a spórák és a micéliuma (gomba vegetatív teste, amely a hifák összessége) adja. Például a fekete színért az Aspergillus niger, a fakózöldért a Penicillium expansum, a kékért pedig a Penicillium Roqueforti felelős.
Bizonyos penészgombák mérgező anyagokat termelnek, amelyeket mikotoxinoknak nevezünk. A mikotoxinok másodlagos anyagcseretermékek, amelyek a növényi és állati sejtekre, az emberre toxikusak. Nagyon hatékony mérgek, igen kis koncentrációban hatnak, és a kis dózisok hatása összegeződhet a szervezetben. Az azonnali tünetek hányás, hasmenés, remegés, bőrkiütések lehetnek. Huzamosabb mikotoxin bevitel esetén többek között rákkeltő, fejlődési rendellenességet okozó, szaporodóképességet csökkentő, immun- és idegrendszert károsító hatások jelentkeznek.
Miért penészedik meg az étel? Okok és tényezők
A penészgombák bárhol megtalálhatók a levegőben, de ahhoz, hogy megtelepedjenek, számos külső és belső tényező megléte szükséges.
Külső tényezők:
- Környezeti feltételek: Szaporodásukhoz általában a savas közeget (pH<6), a 20-25°C-os hőmérsékletet, nedvességet kedvelik. Oxigén hiányában a spórák nem képesek kicsírázni, de egy ideig életképesek maradnak.
- Hőmérséklet: A penészgombák általában szobahőmérsékleten szaporodnak, de találunk közöttük olyan fajokat is, amelyek a hűtőben tárolt élelmiszereken is elszaporodnak. Hűtött húsok felületén, ha az gyorsan kiszárad, szembetűnő penészes romlás következhet be (például Cladosporium elszaporodása fekete foltokat, a Penicillium fajok zöldet, a Sporotrichum és Crysosporium fajok pedig fehér foltokat hozhatnak létre).
- Hőtűrő penészgombák: A hőtűrő penészgombák (pl. Byssochlamys fulva, Byssochlamys nivea, Neosartorya fischeri) jellemzően a hőkezelt gyümölcsök és gyümölcskészítmények romlását okozzák.
- Oxigén: Bár oxigénhiányban a spórák nem csíráznak ki, a penészgombák többsége aerob, tehát szüksége van oxigénre a növekedéshez.
Belső tényezők:
- Élelmiszer összetétele: Idesoroljuk a penészgombák anyagcsere-képességét és a szaporodási sebességét. Szaporodásuk folyamán felhasználják az élelmiszer összetevőit (víz, szénhidrát, nitrogén, ásványi anyagok), és anyagcsere-termékeket (fehérjéket, toxinokat) választanak ki. Az élelmiszer fizikai, kémiai és érzékszervi tulajdonságait megváltoztatják, ami az élelmiszer romlásában jelentkezik.
- Alapanyag minősége: Élelmiszer-biztonsági szempontból fontos a penészgombák nagyfokú jelenlététől és toxinjaitól mentes alapanyag. A feldolgozásra, közfogyasztásra szánt alapanyag ellenőrzött, megbízható helyről kell származzon. Például gabonafélék esetében nemcsak a kémiai eljárások (pl. adalékanyagok) alkalmazásával csökkenthető a fertőzöttség rizikója, hanem fontos a termőföldi gombafélék (Fusariumok) és a tárolás során az ún. raktári penészek (a Penicillium és az Aspergillus fajok) elleni védelem is (aratás, szárítás, őrlés, tárolás, szellőztetés, átforgatás).
A Fuzárium és a mikotoxinok: Rejtett veszélyek
A fuzárium penészgomba leggyakrabban gabonaféléken telepszik meg, mikotoxinjai bekerülhetnek a gabonakészítményekbe is. Mivel ezek a toxinok nem bomlanak le hő hatására, a mérgezéses tünetek feldolgozott élelmiszerek fogyasztása nyomán is jelentkezhetnek. Magyarországon az ellenőrzött forrásból származó gabonakészítmények fuzáriumtoxin-tartalmát ellenőrzik.

Mit tegyünk a penészes élelmiszerekkel? Irányelvek és táblázat
Manapság az a közhiedelem látott napvilágot, miszerint az ételeken, élelmiszereken megjelenő penészfoltok természetesnek vehetők, amelyek révén valamiképpen megbizonyosodhatunk arról, hogy a vásárolt termék hagyományos módon készült, és alig, vagy egyáltalán nem tartalmaz adalékanyagot, tartósítószert. Ez a nézet azonban veszélyes tévedés.
Ha penészes ételt/élelmiszert talál a konyhában, kövesse az alábbi irányelveket:
- Ne szagolgassa a penészes terméket, mert légzőszervi problémát okozhat.
- Ha az élelmiszert teljesen beborítja a penész, zacskóban lezárva dobja ki.
- Tisztítsa meg és a háztartásban használatos készítménnyel fertőtlenítse a helyet, ahol a penészes élelmiszert tárolta.
- Ellenőrizze a penészes élelmiszer közelében lévő termékeket, hogy nem fertőződtek-e.
1. táblázat: Penészes ételek/élelmiszerek kezelése
| Étel/élelmiszer | Teendő | Magyarázat |
|---|---|---|
| Kenyerek és péksütemények | Kidobni | A lyukacsos-szivacsos élelmiszerekben behálózták az étel mélyebb rétegeit is. |
| Gyümölcsök, zöldségek, kemény állagúak (káposzta, sárgarépa, stb.) | Használható. A penészes folt körül legalább 2,5 cm-t vágjunk le (a felülfertőződés megelőzése érdekében a kés éle ne érintkezzen a penésszel). | A kemény állagú élelmiszerekben a penész kevésbé tud behatolni. |
| Gyümölcsök, zöldségek, puha állagúak (uborka, barack, paradicsom stb.) | Kidobni | A puha állagú gyümölcsök, zöldségek a felszín alatt is fertőzöttek lehetnek. |
| Száraz hüvelyesek és olajos magvak | Kidobni | A tartósítószertől mentes élelmiszereknek nagy a kockázatuk a penészedésre. |
| Lekvárok, dzsemek | Kidobni | A penész mikotoxint termelhet. Szakemberek nem javasolják a penészes réteg eltávolítását, és a maradék elfogyasztását. |
| Téliszalámi és a szárazon pácolt sonka (pl. serrano, pármai sonka) | Használható. Dörzsöljük le a penészt a felszínről. | Ezeknél az élelmiszereknél természetes, hogy penészes legyen a felszíne. |
| Löncshús, bacon, vagy virsli | Kidobni | Magas nedvességtartalmú élelmiszerekben szétterjedhet az egész termékben. A penészes élelmiszerekben a baktériumok is elszaporodhatnak a penészgomba mellett. |
| Főtt, sült húsmaradék | Kidobni | Magas nedvességtartalmú élelmiszerekben szétterjedhet az egész termékben. A penészes élelmiszerekben a baktériumok is elszaporodhatnak a penészgomba mellett. |
| Kemény sajtok (olyan sajtok, amelyek előállítása során nem használnak nemes penészt) | Használható. A penészes folt körül legalább 2,5 cm-t vágjunk le (a felülfertőződés megelőzése érdekében a kés éle ne érintkezzen a penésszel). A maradék sajtot új fóliába csomagoljuk. | A kemény állagú élelmiszerekben a penész kevésbé tud behatolni. |
| Nemes penésszel érő sajtok (Roquefort, gorgonzola, brie, camembert, stb.) | A lágy sajtokat, mint a brie és a camembert dobjuk ki, ha olyan penészt észlelünk ami nem a sajtkészítéshez szükséges nemes penész. A kemény sajtoknál, mint a gorgonzola, vágjunk le a penész körül legalább 2,5 cm-t. | A penész nem a gyártási technológia része, ezért az egészségre ártalmas lehet. |
| Lágy sajtok (krém-, friss-sajtok, stb.), reszelt és szeletelt sajtok | Kidobni | Magas nedvességtartalmú élelmiszerek a felszín alatt is fertőzöttek lehetnek. A reszelt, szeletelt sajtokat a vágó, aprító eszköz is felülfertőzheti. A penészes lágy sajtokban a baktériumok is elszaporodhatnak a penészgomba mellett. |
| Joghurt és tejföl | Kidobni | Magas nedvességtartalmú élelmiszerek a felszín alatt is fertőzöttek lehetnek. A penészes élelmiszerekben a baktériumok is elszaporodhatnak a penészgomba mellett. |
| Főtt, sült zöldségek, rakott ételek | Kidobni | Magas nedvességtartalmú élelmiszerek a felszín alatt is fertőzöttek lehetnek. A penészes élelmiszerekben a baktériumok is elszaporodhatnak a penészgomba mellett. |
| Főtt gabonafélék és tészta | Kidobni | Magas nedvességtartalmú élelmiszerek a felszín alatt is fertőzöttek lehetnek. A penészes élelmiszerekben a baktériumok is elszaporodhatnak a penészgomba mellett. |
A Nemzeti Élelmiszerlánc-biztonsági Hivatal (NÉBIH) felmérése szerint a gyerekek többsége (63,6%) nem enné meg a penészes lekvárt, míg 31,4% úgy véli, hogy eltávolítva a penész felszínét fogyasztható. Azonban a szakemberek nem javasolják a penészes réteg eltávolítását és a maradék elfogyasztását.
Mi történik, ha penészt eszel?
Különleges figyelmet igénylő csoportok: Csecsemőknek, várandós anyáknak, immunszupprimált betegeknek (AIDS, HIV, daganatos megbetegedések, stb.), Candida-fertőzésben, és erős gyógyszeres kezelések (pl. kemoterápia) alatt állóknak a friss, zsenge, megbízható élelmiszerek fogyasztása javasolt. A penésszel szennyezett élelmiszerek, még a penésszel érő sajtok sem ajánlottak számukra.
Hogyan előzhető meg az étel/élelmiszer penészedése?
Az élelmiszeriparban használt mikrobás fertőzések elleni védekezés lehetőségei a fizikai, kémiai és kombinált módszerek valamelyike. Ezekkel elsősorban a penész- és élesztőgombák szaporodását gátolják, a minél hosszabb eltarthatóság érdekében.
- Fizikai eljárások: Hőmérséklet csökkentése, növelése, ülepítés, centrifugálás, sugárzások, levegő kizárása (légzáró csomagolás), víztartalom csökkentése.
- Kémiai eljárások: Tartósítószerek alkalmazása (engedélyezett mennyiségben), mint például kénessav, benzoesav, szorbinsav, propionsav.
Háztartási megelőzési tippek:
- Fedje le az ételt tálalásnál, tárolásnál, hogy megakadályozzuk a levegőben lévő spórák megtelepedését.
- Használjon erre a célra alkalmas műanyag fóliát vagy lefedhető tároló edényt a friss, szeletelt gyümölcsök és zöldségek, saláták nedvességtartalmának megőrzése érdekében.
- A felbontott konzerveket öntse át tiszta, fedéllel ellátott edénybe, és haladéktalanul tegye hűtőszekrénybe.
- A romlandó ételeket ne hagyja szobahőmérsékleten 2 óránál tovább.
- A maradék ételeket használja fel 3-4 napon belül.
- Rendszeresen tisztítsa a hűtőszekrényt (pl. szódabikarbónás vízzel).
- Tartsa tisztán a konyharuhákat, szivacsokat, törlőkendőket.
- A lakás levegőjének páratartalmát tartsa 40% alatt.
- Szellőztessen rendszeresen, különösen ruhaszárítás után.
- Kerülje a ruhák fürdőszobában történő szárítását.
- Ha lehetséges, hagyjon szellőzőrést a hideg falak előtt álló szekrények mögött.
- Fontolja meg párátlanító használatát.
Penész a lakásban: Egészségügyi kockázatok és kezelési lehetőségek
A mennyezeten, az ablakok, vagy a bejárati ajtó sarkaiban megbúvó penész könnyen észrevehető. Ha azonban látszólag minden ok nélkül, hosszabb ideje tartó orrdugulás, köhögés gyötri a lakásban, ideje benéznie a szekrények, falvédők mögé!
A penészgombák a földi élővilág szükséges és elengedhetetlen részei. Nem mindig látjuk őket, de a levegőben kisebb-nagyobb mennyiségben mindenhol jelen vannak, lebontó munkájuk nélkülözhetetlen. Miattuk alvad meg a tej, kezd forrásnak indulni a bor, és számtalan sajtot is a nemes penész megjelenése után fogyasztunk, valamint nélkülük a tradicionális téliszalámi sem lenne ugyanaz. Bizonyos penészfajtákért már nem lelkesedünk ennyire. Ezek jól ismert fekete vagy sötétzöld foltokban jelennek meg.
A penész spórákkal terjed. Ezek majdnem mindenhol megtalálhatóak a levegőben, és bizonyos mértékig nem is okoznak gondot. A szakemberek a lakótérben köbméterenként legfeljebb 200 gombaelemet tartanak elviselhetőnek. 200 és 500 közötti jelenlétük már megterheli a légzőszerveket és az immunrendszert. Elsősorban az eleve érzékeny vagy asztmás embereknél okoz felső légúti panaszokat, ha penészes levegőjű szobában tartózkodnak. A WHO is kitér a penészes levegő veszélyeire. Ha korán, már csecsemő- vagy gyermekkortól ki vagyunk téve a penészes közegnek, ez megnöveli az asztma kialakulásának kockázatát, különösen azoknál a gyerekeknél, akik genetikusan hajlamosabbak rá. Azok is veszélyben vannak, akiknek legyengült az immunrendszerük.
Természetes és otthoni penészirtó szerek:
- Ecet: A 20%-os ecet a gombák és a baktériumok több mint 80%-át elpusztítja. Érdemes szórófejes pumpát használni és alaposan átitatni az érintett részt. Hagyjuk pár óráig hatni, majd egy kefével (a sarkokban akár fogkefével) dörzsöljük le a foltokat! A szaga kellemetlen lehet, így alaposan ki kell öblíteni.
- Teafaolaj: A természet leghatékonyabb fertőtlenítőszere. 2 dl vízhez 1 teáskanálnyi olajat használjunk! Jól rázzuk fel! Legegyszerűbb pumpás adagolóval felvinni a felületre. Várjunk 1-2 órát, majd súroljuk le!
- Citrusmag kivonat: Polifenolok és naringin tartalmának köszönhetően remek baktérium- és gombaölő.
- Szódabikarbóna: Biztonságos, nem veszélyes, ugyanakkor nagyon hatékony a penészedés megelőzésében és a kellemetlen szagok eltüntetésében. Fele-fele arányban keverjük össze vízzel, amíg nem kapunk egy masszaszerű anyagot!
- 70%-os alkohol: Megöli a penészgombát azáltal, hogy elvonja a gomba víztartalmát. A bőségesen kifújt alkoholt 3-5 perc után töröljük át.
- Hidrogén-peroxid (3%-os oldat): Széles spektrumú antimikrobiális háztartási tisztítóként használható. A kész oldat rövid ideig tárolható sötét üvegedényben vagy fénytől elzárt helyen.
Ami káros, lehet hasznos is: A penész kettős természete
Számos penészgomba a romlást okozó és toxintermelés helyett/mellett értékes anyagokat képez. Ilyenek az antibiotikumok (pl. penicillin - Penicillium chrysogenum), alkaloidák, más gyógyszer-alapanyagok, szerves savak, enzimek (pl. amiláz - Aspergillus niger). A penészgombák néhány faját az élelmiszeripar felhasználja fermentált, erjesztett, érlelt készítmények előállításához. Ilyenek a különböző sajtok (pl. camembert, roquefort) érleléséhez felhasznált gombák, a szalámikon található „nemes penészek”. A hideg hónapokban a párakicsapódás miatt rengetegen küzdünk a penészedéssel. A penész sajnos károsítja az egészségünket, a gyerekekre különösen veszélyes. A penészgombák a földi élővilág szükséges és elengedhetetlen részei. Nem mindig látjuk őket, de a levegőben kisebb-nagyobb mennyiségben mindenhol jelen vannak, a lebontó munkájuk nélkülözhetetlen. Miattuk alvad meg a tej, kezd forrásnak indulni a bor, és számtalan sajtot is a nemes penész megjelenése után fogyasztunk, valamint nélkülük a tradicionális téliszalámi sem lenne ugyanaz. De arról is egy penészgomba tehet, hogy Tokajban aszúsodott szőlőszemeket lehet szüretelni.
Összefoglalva, bár a penész sok esetben aggodalomra ad okot, fontos megkülönböztetni a potenciálisan káros fajtákat a jótékony vagy ártalmatlanoktól. A tudatos táplálkozás, a megfelelő higiénia és a megelőzés kulcsfontosságú az élelmiszerbiztonság szempontjából.